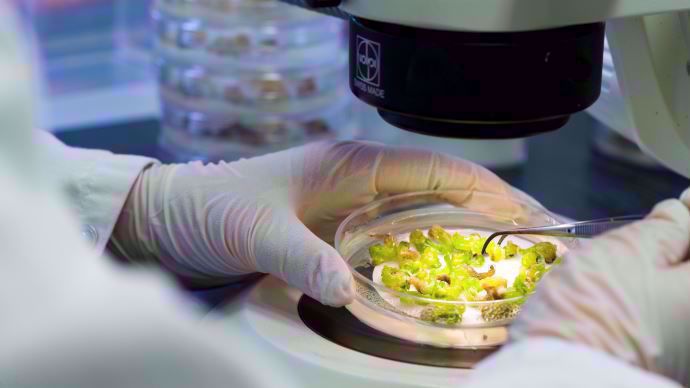
Formulation de Rhapsody Formulation de Rhapsody

Les bactéries sont présentes par millions dans la nature. L’une d’elles, Bacillus subtilis QST 713, récemment découverte par Bayer, présente un grand nombre de qualités. La diversité et la quantité de composés naturels qu’elle est capable de produire sont particulièrement intéressantes, à condition toutefois de bien « l’alimenter » et de la placer dans des conditions idéales de croissance. Une recette de fermentation affinée ces dernières années par les chercheurs de la firme. Sa formulation est désormais parfaitement au point.
Une formulation stable
Élaborer un produit de biocontrôle, composée d’organismes vivants, stable représente un véritable défi. Comment Rhapsody® est-il fabriqué ? L’ajout de nutriments dans un fermenteur permet aux bactéries de grandir et se multiplier ; ce faisant, elles sécrètent des composés naturels aux activités antifongiques et antibactériennes. Une fois ces nutriments assimilés, les bactéries se transforment en spores de conservation, appelées endospores : un état stable qui empêche la formulation d’évoluer une fois conditionnée en bidon. Un process rigoureux, basé sur le contrôle et l’évaluation à chaque étape, garantissant la qualité et la durabilité du produit final.
Des lipopeptides à action fongicide
Rhapsody® contient principalement trois types de composés naturels, sécrétés pendant la fermentation : inhibiteurs d’enzymes bactériennes, hormones végétales et un complexe de lipopeptides. Parmi ces derniers, trois ont une action fongicide différente et complémentaire :
- Les iturines perturbent les membranes des cellules des pathogènes et les détruisent. Elles inhibent la germination des spores et provoquent la rupture des membranes plasmiques.
- Les agrastines détruisent le mycélium en croissance en fragilisant ses membranes.
- Les surfactines renforcent l’action des deux premiers.
Les inhibiteurs d’enzymes bactériennes (macrolactines et difficidines) sont des molécules à action bactéricide qui bloquent la synthèse des protéines, tout comme la division cellulaire du parasite. Enfin, les hormones végétales (indole-acetic-acid et butanédiol) stimulent la croissance de la plante et renforcent ses défenses naturelles.

